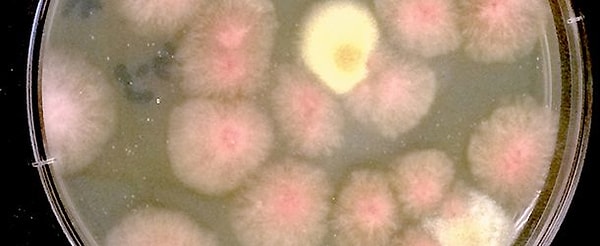
1. Бактерии

Неприятные факты о космических полётах, о которых вы раньше точно не догадывались
Все думают о космосе и космических путешествиях как о какой-то следующей ступени развития человечества. Космонавтов считают людьми, которым как будто бы доступен выход в другую Вселенную. Однако никто даже не задумывается об обратной стороне медали. Как ходить в туалет или чихать? Что есть? Обо всех этих и прочих не очень приятных тяготах 'космической' жизни мы расскажем прямо сейчас.
1. Бактерии
Думали, что космос - это нечто стерильное, а наличие бактерий ему чуждо? Это вовсе не так. Космический аппарат изнутри такой же грязный, как ваша квартира, которую не убирали примерно неделю. Учёные нашли в космосе около 4000 различных бактерий.
2. Космическая болезнь

Космос - место, где напрочь отсутствует гравитация, вследствие чего многие космонавты страдают от синдрома космической адаптации или, как его ещё называют, космический болезни. По симптомам это состояние схоже с морской болезнью: снижение аппетита, головокружение, головная боль, усиление слюноотделения, тошнота, иногда встречается рвота, пространственные иллюзии.
3. Слизь из носа

На земле слизь вытекает из носа, когда мы чистим его. Но из-за отсутствия гравитации в космосе дела обстоят абсолютно по-другому - слизь остаётся в носовых пазухах. Единственные способы от неё избавиться - горячая пища или острые соусы.
4. Мозг

В космосе кровоток работает совершенно иначе. Около 4 дней космонавты ходят с лицами, опухшими от избыточного количества крови в районе мозга. Но потом организм адаптируется, и всё становится на свои места.
5. Специи

Это на Земле вы можете добавить в еду соль или перец, а вот в космосе эти специи просто будут разлетаться и частицами парить в воздухе. Поэтому соль и перец космонавты используют в жидкой форме.
6. Отмершие клетки кожи

В жизни мы даже не замечаем, как теряем отмершие частички кожи, но вот из-за отсутствия гравитации в космосе они будут летать целыми хлопьями по всему космическому аппарату.
7. Еда из тюбиков

НАСА раньше не очень-то и заботились о еде для космонавтов, поэтому астронавт Джон Гленн и многие другие попросту отказывались есть эту пищу.
8. Запах в открытом космосе

Люди, которые побывали в космосе, говорят, что он пахнет горелой помойкой и прочими вещами, а вот Луна - пороховой гарью.
9. Подгузники для космонавтов

Это специальные трусики с повышенной впитываемостью влаги, которые используются, когда у космонавтов нет возможности быстро снять скафандр и сбегать в туалет.
10. Неожиданное мочеиспускание

Из-за особенностей гравитации жидкость в мочевом пузыре накапливается не так, как на Земле. Пузырь может резко наполниться до предела, и вы поймёте, что просто не успеваете добежать до туалета.
11. Употребление собственной мочи

В космосе с водой напряжёнка, поэтому космонавты используют специальный аппарат, который перерабатывает их мочу в питьевую воду. Он стоит, на минуточку, 250 тысяч долларов!
12. Метеоризм

Пукнуть в космосе так, как на Земле, не получится - от этого может начаться рвота. Именно поэтому космонавты выработали специальную технику, которая помогает им избавиться от вздутия живота без последствий.
13. Дефекация в космосе

Раньше космонавты при испытывании нужды пользовались специальными пакетиками, но затем космическая промышленность шагнула вперёд и изобрела самый настоящий туалет. Однако на нём тоже стоит справлять нужду правильно, иначе фекалии могут попасть совсем не туда, куда нужно.
14. Чихание

Поскольку в скафандре нет возможности закрыть рот или нос рукой, слизь и сопли могут залепить его стёкла, что пагубно скажется на видимости, именно поэтому космонавты стараются чихать вниз, а не перед собой.
15. Смерть в космосе

В случае смерти кого-нибудь из членов экипажа его тело укладывается в специальный чехол, внешне напоминающий спальный мешок, который затем прикрепляется снаружи космического аппарата. В результате труп должен полностью сгореть при входе космического корабля в верхние слои атмосферы Земли.
Keşfet ile ziyaret ettiğin tüm kategorileri tek akışta gör!


Напишите комментарий